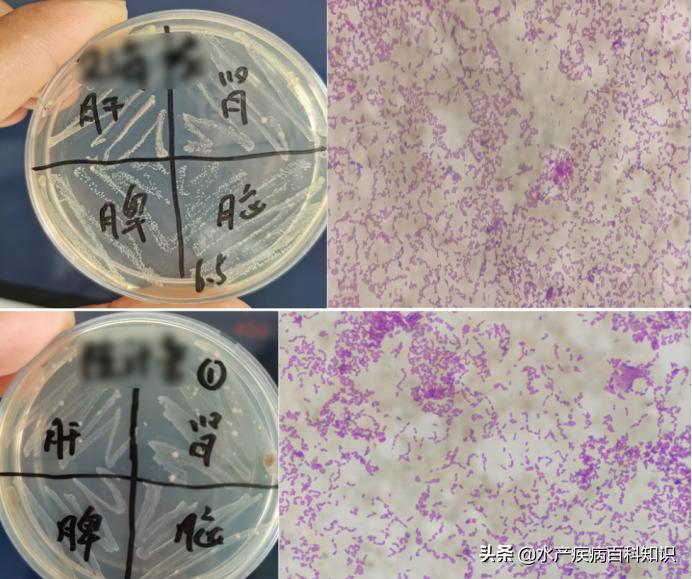
罗非鱼链球菌病治疗措施,罗非鱼感染链球菌病发病原因

海南翁田地区罗非鱼在每年高温期发病情况越来越严重。根据近期跑塘技术服务和顾客检测结果来看,罗非鱼塘出现不同程度的死鱼,少则几十尾到几百尾,多则1000多到2000尾。许多养殖户根据他们的经验用药,有好药或坏药。大部分处理思路为有死鱼就杀虫、消毒,再轮流内服抗菌药,部分也能够治愈,没有处理好的,则会延误病情,增加治疗难度,造成损失。,总结分析该地区罗非鱼发病的基本情况,及处理存在的问题,并提出有效防控建议。
一、主要发病症状及原因分析
发病罗非鱼的主要症状表现为:体表及鳍条出血,肛门红肿,鳃盖内缘出血充血,脾脏发黑,肝脏萎缩,肠道发红充血,和套肠等症状。
5、6月份天气反复无常,经常出现白雨。水温为25至37°C。池塘水质变化很大,藻类大量死亡,氨氮和亚硝酸盐迅速上升,水体非常不稳定。经过大量调查总结发现,所有池塘都有一些共同点:
①水体浑浊,经常翻底,池塘溶解氧低;
②池内藻类老化,倒藻或死藻较多;
③4~5月份投喂足,1万斤鱼投喂量超过3包料(150斤),池塘污染严重;
④解剖肝脏差、肠炎、套肠症状明显的发病鱼,接种组织进行细菌分离培养,多数分离出大量链球菌、少量气单胞菌。

发病鱼脾脏发黑,肝萎缩,胃、肠道充血

发病鱼套肠
发病鱼细菌分离大部分为链球菌,少量气单胞菌
二、处理效果分析及防控方案
多数池塘发病后,采取内服药物进行处理,可往往效果不尽人意。跟踪发现治疗不理想的主要原因是:
①气泡病诱发及加重发病;
②内脏和肠道受损,消化吸收差,体质弱;
③盲目消毒、杀虫,破坏水体稳定;
④没有根据药敏试验结果针对性用药,导致治疗效果差。针对发病情况及处理存在的问题进行分析,建议从以下方面着手加强防控。
预 防:
①多开增氧机(1万斤鱼1台1.5kW增氧机),促进增氧曝气,减少缺氧及气泡病的影响;②使用“ 底无忧 ”改底,减少返底中毒,减少倒藻水变;
③高温期闷热天气减少投喂,1万斤鱼100斤料/天;
④定期7天使用一次“ 藻益多 ”,调水稳藻;
⑤坚持内服“ 肝胆无忧 ”保肝增强体质,减少发病。
处 理:
①加大增氧,减料1/2或者2/3,减轻肝脏负担及水质污染;
②外用“水无忧”,解毒调水,改善环境;
③ 外泼加拌料内服国标纯中药制剂组方《鳃腐康》+《肝胆无忧》+《银翘板蓝根散》,富含多种名贵中草药,促凝血止血,恢复伤口,杀灭细菌,恢复肝胆器官功能,纯中药成分不伤肝胆,不伤水质,定期预防更省心!
三、处理案例分享
海南省杨老板养殖罗非鱼,面积50亩,水深2.5米,放养罗非鱼10万尾,目前平均规格在8~9两/尾。4台叶轮式增氧机,白天下午1点开到4点,晚上10点开到第二天12点。检测氨氮0.2mg/L 亚硝酸盐无,pH值8.6,溶解氧6mg/L左右。老板反映近期下雨过后,鱼吃料没有之前那么-好,10万尾鱼只能吃到18包料,正常一天可以喂到20~21包,靠边鱼增多,死鱼70~80尾,今天已经是第三天。检查多数发病鱼有烂鳃,肝脏充血萎缩,套肠等症状。接种病鱼分离出大量链球菌。
6月11日,使用“ 水无忧 ”解毒,减少氨氮毒性,同时配合调水,白天增氧机全开。
6月12日,内服“ 鳃腐康+肝胆无忧+银翘板蓝根散” ,一天一餐,连续内服5天。
6月13日,使用“ 藻益多 ”,调水稳定藻相。
6月17日回访,死鱼下降至10多尾/天,喂14包料。继续内服,死亡控制在5尾/天以下。
进入高温期后,疾病进入*爆高**发期,一定要定期做好预防工作。